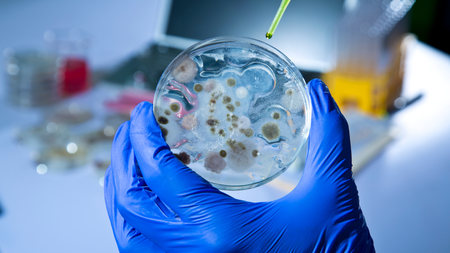
article-post

Neuralink ha trasportato agenti patogeni senza dovute precauzioni?
L'accusa è arrivata dalla Physicians Committee of Responsible Medicine e fa riferimento a fatti che sarebbero accaduti nel 2019
Nel corso della sua (ancor) breve storia, Neuralink è stata al centro di moltissime polemiche. La prima riguarda l’utilizzo indiscriminato di animali (in particolare i macachi) per testare i suoi chip cerebrali e ottenere quei risultati che, nel maggio di quest’anno, hanno portato all’autorizzazione da parte della FDA per la sperimentazione sull’essere umano. Criticità che si sono arricchite, nel mese di febbraio, di una denuncia formale per aver trasportato agenti patogeni in modo non corretto e rischioso, senza seguire gli obblighi prescritti dalla legge americana.
LEGGI ANCHE > Le due volte in cui la FDA ha negato l’autorizzazione a Neuralink
A muovere questa accusa è stata la PCRM (Physicians Committee of Responsible Medicine), un’organizzazione senza scopo di lucro che si occupa della difesa dei diritti degli animali, con un focus specifico sulle sperimentazioni cliniche. In base ad alcuni documenti entrati in loro possesso, ci sarebbero tutti i presupposti affinché l’azienda co-fondata da Elon Musk venga accusa del mancato rispetto della legge federale Hazmat (meglio conosciuta come Hazardous Materials Transportation Act) in cui viene fornito il piano normativo per il trasporto di materiali potenzialmente pericolosi.
Neuralink e l’accusa sul trasporto di agenti patogeni
Secondo la Commissione PCRM – che ha chiesto al Dipartimento Trasporti degli Stati Uniti di aprire un’indagine a riguardo -, le violazioni sono state confermate da una serie di e-mail inviate da un dipendente dell’Università della California-Davis (UC Davis) e i responsabili di Neuralink. In particolare, ci sono due passaggi che sottolineano come il trasporto di materiale organico (e hardware impiantati e poi rimossi da animali deceduti) non abbia rispettato la legge. In una prima comunicazione, il dipendente della UC Davis ha scritto:
«Poiché i componenti hardware del dispositivo neurale espiantato non sono sigillati e non è stato disinfettato prima di lasciare l’università, ciò presenta un pericolo per chiunque possa entrare in contatto con il dispositivo neurale espiantato. Etichettarlo semplicemente come “pericoloso” non tiene conto del rischio di contrarre potenzialmente l’Herpes B».
Un caso isolato? Non sembra proprio essere così. In un’altra mail ottenuta dalla PCRM, un altro dipendente dello stesso Ateneo californiano ha “raccontato” le modalità di consegna di altro materiale proveniente dagli studi clinici di Neuralink:
«I dispositivi sono tornati all’università in una scatola aperta. Stiamo sollevando un grave problema a riguardo perché siamo preoccupati per la sicurezza umana».
Si trattava di un rischio concreto o esasperato? Le cartelle cliniche delle scimmie decedute durante i test su animali, ottenute dai medici della Physicians Committee of Responsible Medicine, hanno dato un indizio sulla concretezza delle preoccupazioni: alcuni esemplari, infatti, presentavano cariche batteriche sintomo di infezione da Staffilococco e Klebsiella, che si vanno ad aggiungere al rischio Herpes di tipo B.
Anno domini: 2019
Tutto ciò risale al 2019. In quel periodo, Neuralink aveva stretto una partnership di collaborazione con l’Università della California-Davis, proprio per lo sviluppo e i test del chip cerebrale in questione. I dispositivi utilizzati, dunque, venivano trasportati dalle stanze dell’azienda co-fondata da Musk e quelle dell’ateneo. Questo accordo di collaborazione terminò nel 2020, ma uno dei neurochirurghi e alcuni membri del team di ricercatori universitari, hanno proseguito il loro rapporto di controllo e supervisione con l’azienda. Ed è proprio in questa fase storica che, secondo le accuse, ci sarebbe stato questo trasporto pericoloso di agenti patogeni, senza seguire le indicazioni previste dalla legge sulla sicurezza dei trasporti di materiali pericolosi per l’uomo e per l’ambiente.